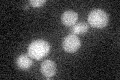
YPR030W
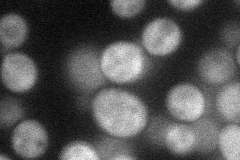
YPR030W
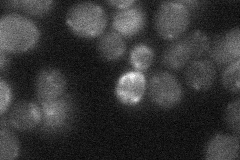
YPR030W
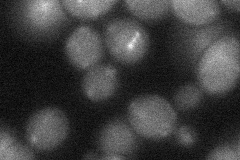
YPR030W

View description
Nuclear protein proposed to regulate utilization of nonfermentable carbon sources and endocytosis of plasma membrane proteins; overproduction suppresses chs5 spa2 lethality at high temp; ubiquitinated by Rsp5p, deubiquitinated by Ubp2p
Localization:
Intensity:
Fold change:
Significance:
-
C’ GFP library in SD
below threshold18.87 -
N' NOP1pr-GFP in SD
cytosol36.2499 -
N' TEF2pr-mCherry in SD

cytosol14.6183 -
N' NATIVEpr-GFP in SD
below threshold18.5079 -
N' TEF2pr-VC and Cyto-VN in SD
cytosol29.855 -
C’ GFP library in SD+DTT

cytosol17.070.9No -
C’ GFP library in SD+H2O2

cytosol24.341.28No -
C’ GFP library in Starvation Media

cytosol28.41.5No -
C’ GFP library on the background of Pup2-DaMP

below threshold -
C’ GFP library on the background of CCT mutant

below threshold17.78680.94209No
